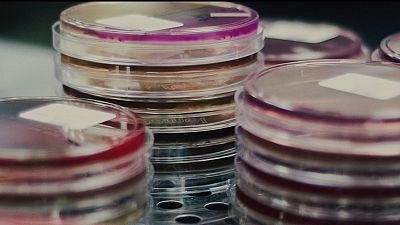
La resistencia a los antibióticos, un problema global tan urgente como el cambio climático o la migración

¿Qué es una infección polimicrobiana respiratoria? El "complejo cuadro clínico" del papa Francisco
- Varios expertos consultados por RTVE.es explican en qué consiste, posibles causas, síntomas y factores de riesgo
- En directo, la última hora sobre la salud del papa Francisco
La salud del papa Francisco ha vuelto a hacer saltar todas las alarmas después de que fuera ingresado el pasado viernes en el Policlínico Gemelli de Roma. La bronquitis que padece desde hace varios días ha afectado a su capacidad para cumplir con su agenda, especialmente a la hora de poder leer sus discursos.
El último comunicado del Vaticano informó que las pruebas realizadas en los últimos días, incluidas las de este lunes, han detectado una "infección polimicrobiana en el tracto respiratorio, lo que ha obligado a ajustar su tratamiento". Además, se señala que "su cuadro clínico es complejo", por lo que requerirá una "hospitalización adecuada".
A pesar de esto, el comunicado indica que el estado del Pontífice permanece "estable" y que ha "descansado bien durante la pasada noche".
Pero, ¿en qué consiste exactamente este tipo de infección respiratoria?
¿Qué es una infección polimicrobiana respiratoria?
El catedrático en Neumología de la Universidad de Zaragoza, José María Marín, explica a RTVE.es que, en realidad, "es un término bastante inespecífico que no corresponde a una entidad clínica definida".
Es decir, no se trata de una enfermedad con un nombre concreto como el asma, la neumonía o la bronquitis aguda. "Se refiere a una situación en la que, en el laboratorio, se aíslan varios microorganismos responsables de la infección, en lugar de uno solo", detalla el experto, que señala que, por lo general, las infecciones respiratorias suelen estar causadas por un único microorganismo".
En este sentido, el profesor de Microbiología de la Universidad Europea del Atlántico en Santander, José Ramos Vivas, añade que "lo que ha ocurrido es que una de las bacterias ha aprovechado una infección previa causada por otro microorganismo, ya sea un virus, otra bacteria o un hongo, para colonizar los tejidos, aprovechando también que el sistema inmunitario estaba ocupado combatiendo la primera infección".
¿Cuáles son las causas más comunes y los factores de riesgo?
Cuando se produce una infección polimicrobiana es porque el organismo afectado no se está defendiendo adecuadamente. "Puede ocurrir cuando hay una patología subyacente, como enfermedades crónicas. Por ejemplo, en niños con fibrosis quística, que son más vulnerables a infecciones porque su sistema inmunológico no responde bien, lo que permite que varios microorganismos crezcan y causen una infección aguda", señala Marín.
Otras enfermedades que pueden generar este tipo de infecciones son la fibrosis pulmonar, la enfermedad pulmonar obstructiva crónica avanzada, y especialmente las bronquiectasias. El neumólogo explica que estas últimas son dilataciones de los bronquios, a menudo causadas por infecciones previas o por el envejecimiento.
"Son más comunes en personas mayores, a partir de los 60 años, debido al deterioro pulmonar. Cuando se colonizan los órganos, pueden provocar infecciones graves, y se encuentran varios microorganismos en las secreciones. No afirmo que esto ocurra en el caso del papa, pero es común en infecciones con múltiples microorganismos". Francisco sufrió una resección pulmonar previa (en su juventud), resultado de una neumonía complicada.
"Ese antecedente médico podría ser una de las causas, ya que, con el tiempo, el pulmón se deteriora y pueden aparecer. Después de varias décadas, los bronquios están más susceptibles a infecciones polimicrobianas", añade el experto.
Otra posible causa es que el paciente tenga una disminución de sus defensas inmunitarias, debido a diversas razones como una debilidad generalizada o, en algunos casos, la presencia de tumores. "Esta debilidad reduce la capacidad del cuerpo para responder a la infección de manera eficiente, lo que hace que el proceso para eliminar la infección sea más largo, incluso si se administran antibióticos y tratamiento de apoyo".
¿Podemos hablar de síntomas característicos?
La infección respiratoria polimicrobiana no es una enfermedad que tenga signos y síntomas concretos. El Pontífice lleva algunos días acarreando una bronquitis cuyos síntomas suelen ser tos persistente, flemas, sensación de falta de aire o fatiga, dolor muscular y de pecho, fiebre baja, sibilancias (sonidos silbantes al respirar), o congestión y secreción nasal, entre otros.
"Podríamos hablar de los síntomas respiratorios que pueden tener la mayoría de las personas cuando tienen bronquitis o cuando tienen neumonía, pero en una infección polimicrobiana la diferencia es que involucra varios microorganismos. Esto puede hacer que los antibióticos habituales no tengan el mismo efecto que cuando se trata una infección única, que generalmente responde bien", explica el neumólogo.
En este sentido, Marín señala que el hecho de que el papa haya sido hospitalizado durante varios días puede sugerir que "la infección es relativamente grave y no está respondiendo adecuadamente al tratamiento", aunque destaca que lo principal es esperar a conocer el cuadro clínico.
Métodos de diagnóstico
En general, cuando un paciente presenta tos, expectoración, infecciones respiratorias recurrentes, etc., lo primero que hacen los médicos es analizar las secreciones en el laboratorio. "Esto es un paso muy común, ya que lo que se busca es estudiar la bacteriología de la infección. En este caso, se ha llegado a la conclusión de que hay varias bacterias involucradas, por lo que se le llama una infección polimicrobiana".
En la práctica clínica habitual, a este tipo de pacientes se les realizan escáneres, diversas pruebas y análisis de sangre. "Estoy seguro de que eso se lo habrán hecho y que ya tendrán el diagnóstico y las causas subyacentes de la infección. Sin embargo, como es comprensible, no contamos con toda la información debido a la discreción médica, especialmente cuando se trata de una figura como el pontífice".
En este sentido, Marín también subraya que cualquier persona con 88 años y con una infección respiratoria tiene un pronóstico de entrada reservado. "Puede ser grave, pero también puede recuperarse perfectamente".
Tratamientos disponibles y su eficacia
José Ramos Vivas explica que, en general, las infecciones respiratorias suelen estar causadas principalmente por virus y, en la mayoría de los casos, no requieren un tratamiento específico, "sino simplemente dejar que el organismo las supere por sí mismo". Ejemplos comunes podrían ser la gripe o los catarros, que suelen resolverse sin complicaciones. "Sin embargo, las infecciones respiratorias más graves suelen ser las provocadas por bacterias, como el neumococo o el Staphylococcus aureus", añade.
En estos casos, José María Marín subraya que lo primero es proporcionar un tratamiento de apoyo con medidas generales para el paciente, como hidratación, nutrición y, en general, asegurar que esté lo más fuerte posible físicamente, para que sus defensas puedan responder de manera eficaz.
"En algunos casos, es necesario hospitalizar al paciente para mejorar su capacidad de defensa. Además, los microbiólogos que han identificado las bacterias estarán probando su sensibilidad a los antibióticos más efectivos, con el fin de desarrollar un tratamiento específico y personalizado", señala Marín, aunque con el añadido de la posible resistencia a los mismos.
Una vez superada la infección aguda, si el paciente sigue teniendo presencia de bacterias en sus pulmones, existen antibióticos nebulizados (aerosol que se inhala y llega directamente a las vías respiratorias y pulmones) que pueden utilizar en casa. "Estos medicamentos se administran de forma regular para prevenir sobreinfecciones o evitar que se produzcan agudizaciones que lleven a otra hospitalización". Se trata de un proceso puede durar desde varios meses hasta varios años, y requiere un seguimiento a medio y largo plazo para asegurar su eficacia.
En cuanto al tiempo promedio de recuperación, Marín señala que es difícil de determinar, ya que "la presentación clínica de estos pacientes puede ser bastante variable" y, en el caso del papa Francisco, desconocemos los problemas subyacentes.
¿Qué potenciales complicaciones existen?
En estos casos, el acceso temprano a la asistencia sanitaria es clave. "No podemos saber exactamente qué ocurrió en cada caso, pero si hay una demora en la administración de tratamientos específicos dirigidos a las bacterias responsables, la infección puede progresar".
“La presentación clínica de estos pacientes puede ser bastante variable“
La infección puede no solo agravarse en el órgano afectado, en este caso el aparato respiratorio, sino que también puede extenderse más allá de los pulmones y diseminarse por el torrente sanguíneo, lo que se conoce como sepsis. Esto, aunque poco frecuente, puede ocurrir.
"Afortunadamente, en países con sistemas de salud desarrollados, las infecciones como la bronquitis aguda o las neumonías suelen tratarse a tiempo, lo que reduce significativamente el riesgo de sepsis. Sin embargo, la principal complicación en estos casos sigue siendo el retraso en la atención médica, que permite que la infección se propague fuera del pulmón y se vuelva más difícil de controlar", detalla.
"Curarse y cuidarse bien"
Según Marín, las buenas prácticas frente a este tipo de infecciones pasan por hacer un uso adecuado de los antibióticos, así como un diagnóstico preciso del problema subyacente. "Estos pacientes deben ser gestionados por especialistas, con un enfoque cuidadoso. Es fundamental administrar los antibióticos en el momento adecuado, siempre con un control bacteriológico que permita identificar qué antibiótico es el más adecuado para tratar el microorganismo en cuestión".
En cuanto a la prevención, el microbiólogo José Ramos Vivas destaca "no hay ninguna medida que pueda prevenir una infección de este tipo. Somos incapaces de protegernos frente a una sola bacteria, imagínate frente a dos o tres, es decir, no se puede predecir". Sin embargo, cuando sucede, señala que lo fundamental es evitar el peligro de la cronicidad.
"Es importante cuidarse y curarse bien, ya que, a la larga, puede hacer que lo acabes desarrollando cada uno o dos años, y no se te quita".